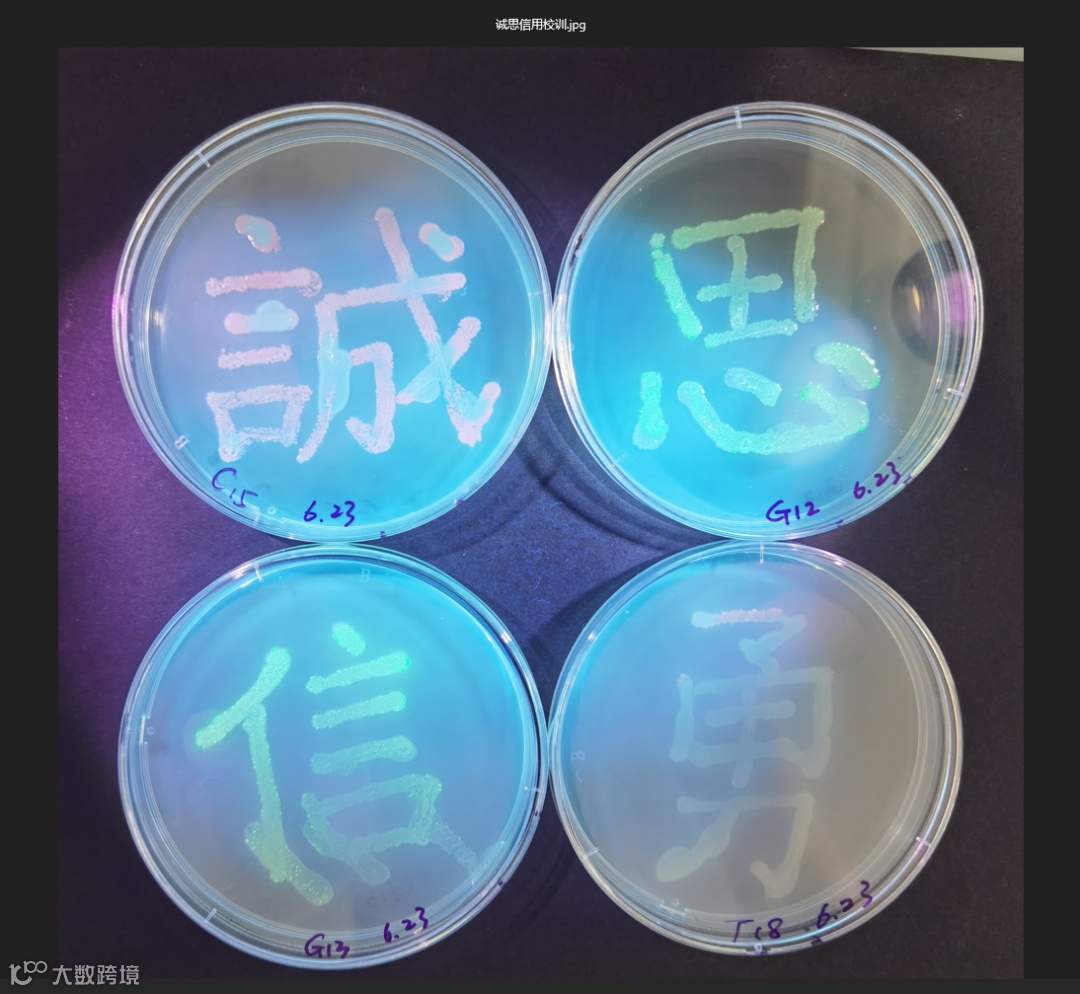
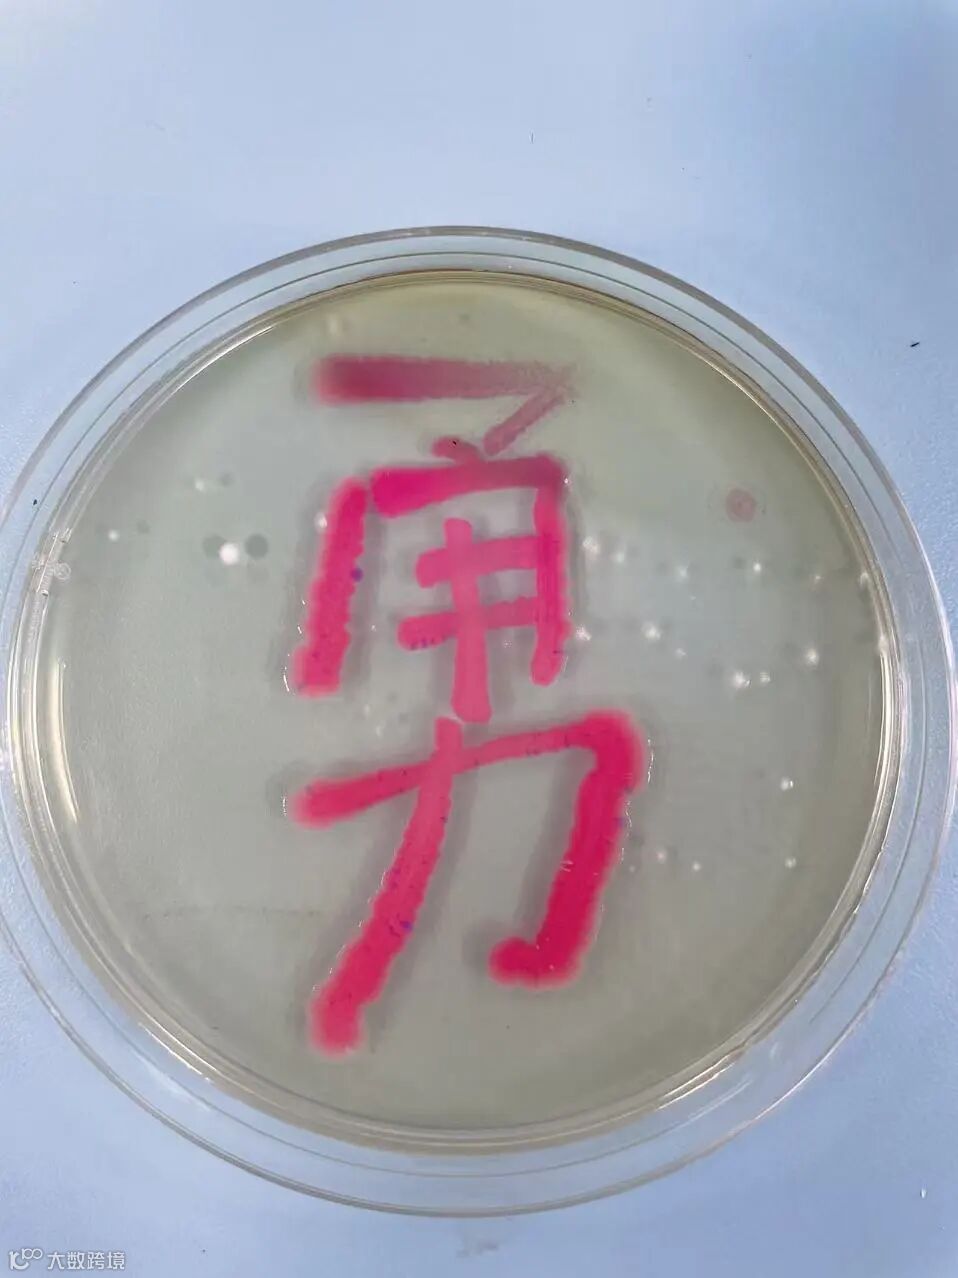
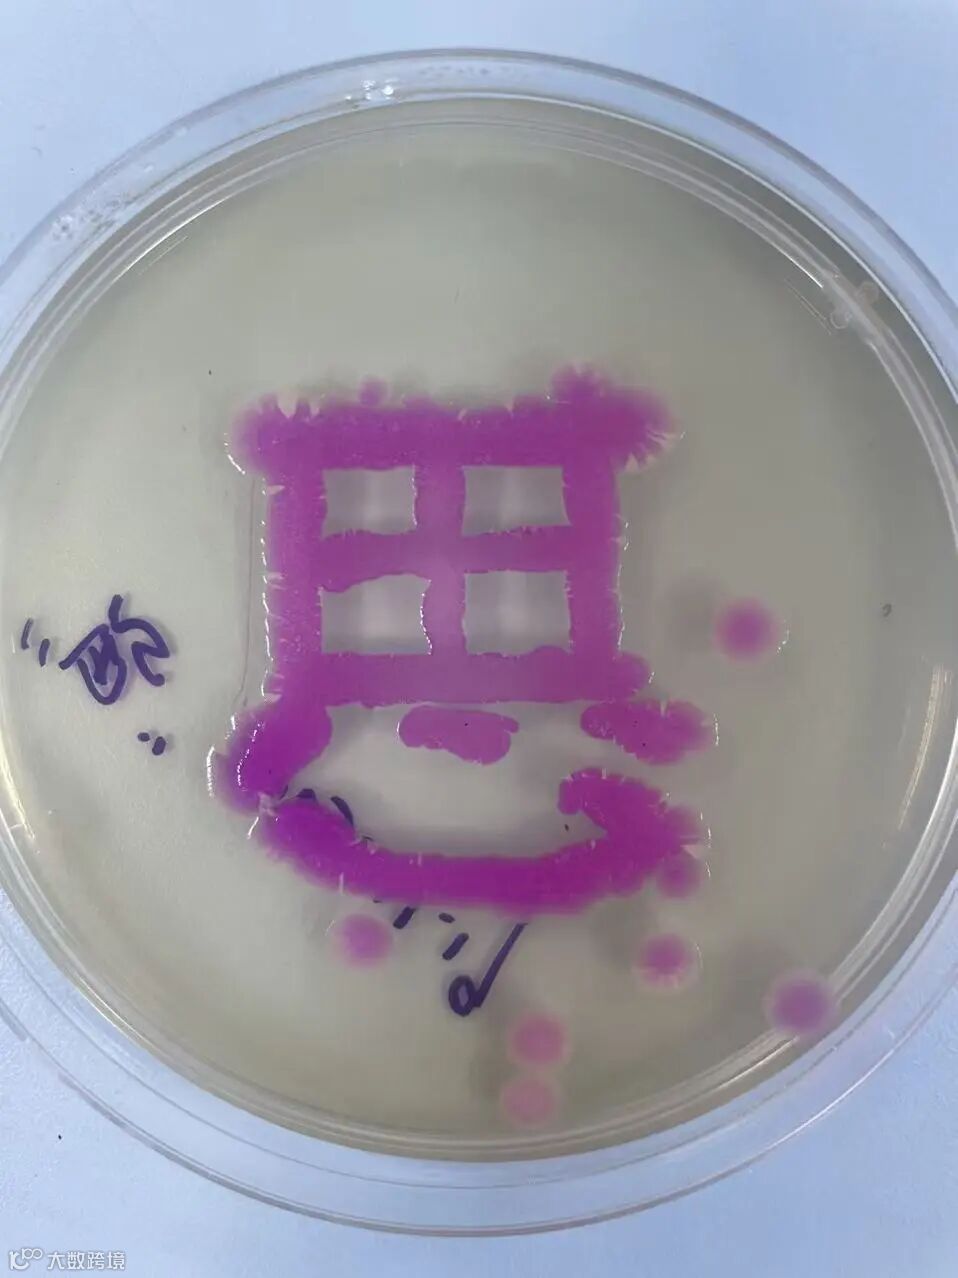
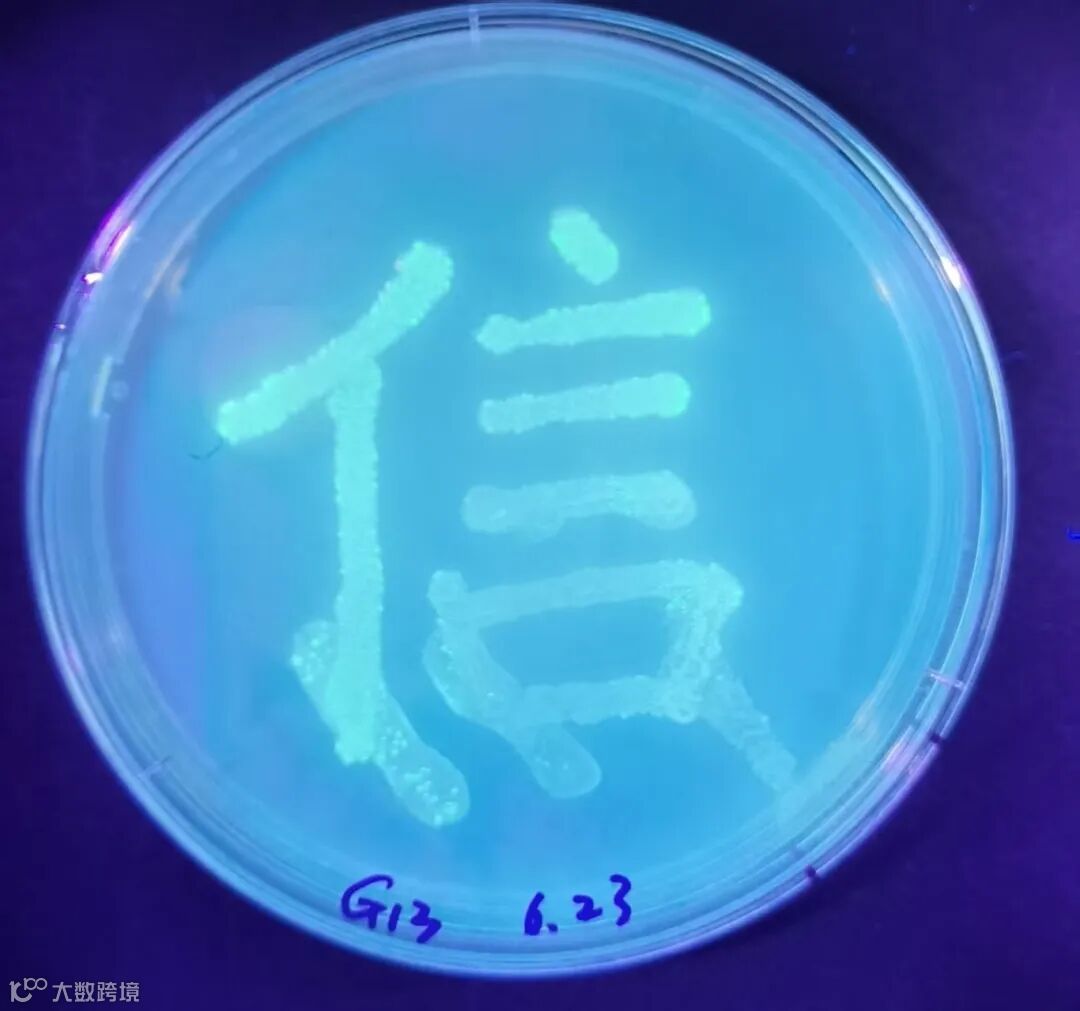
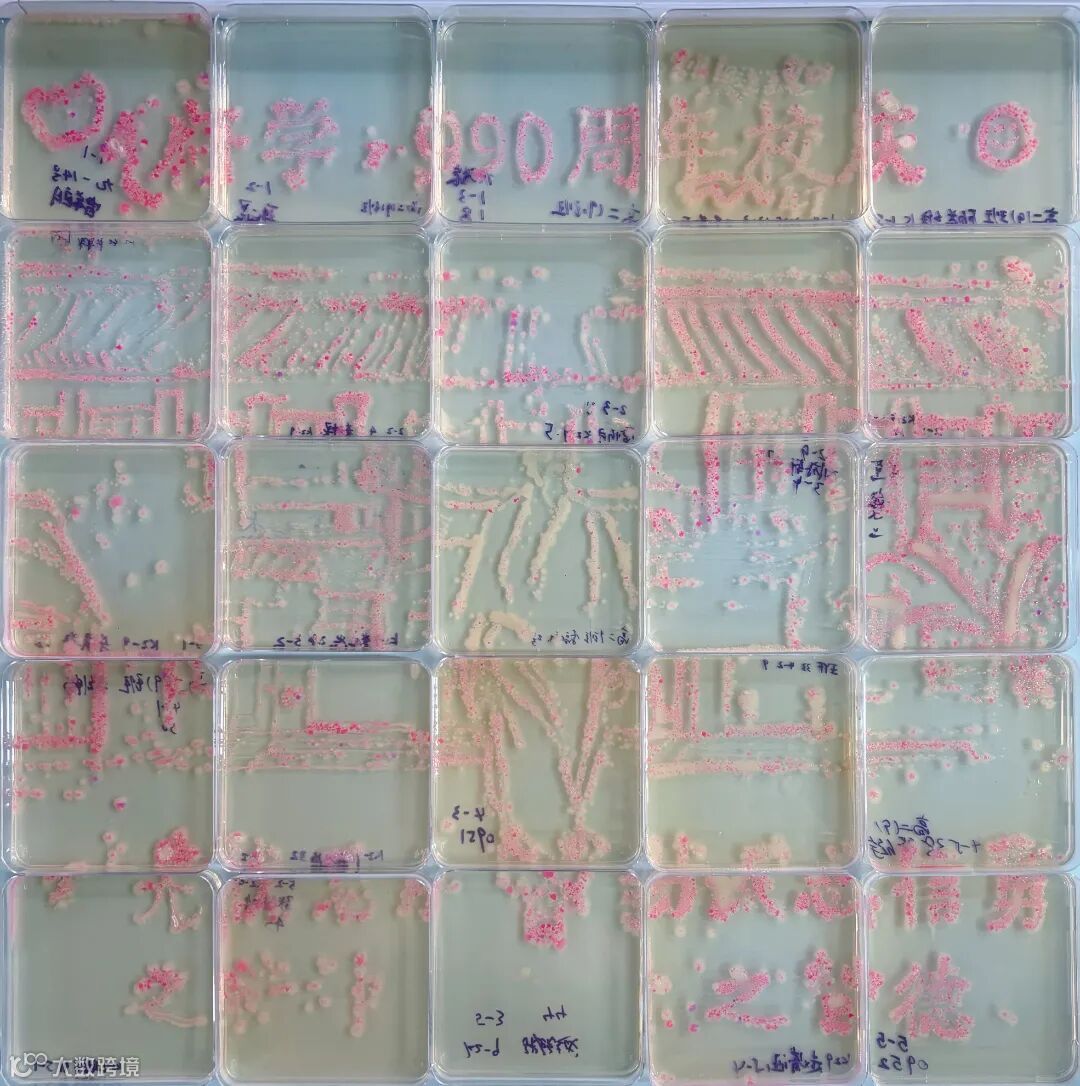
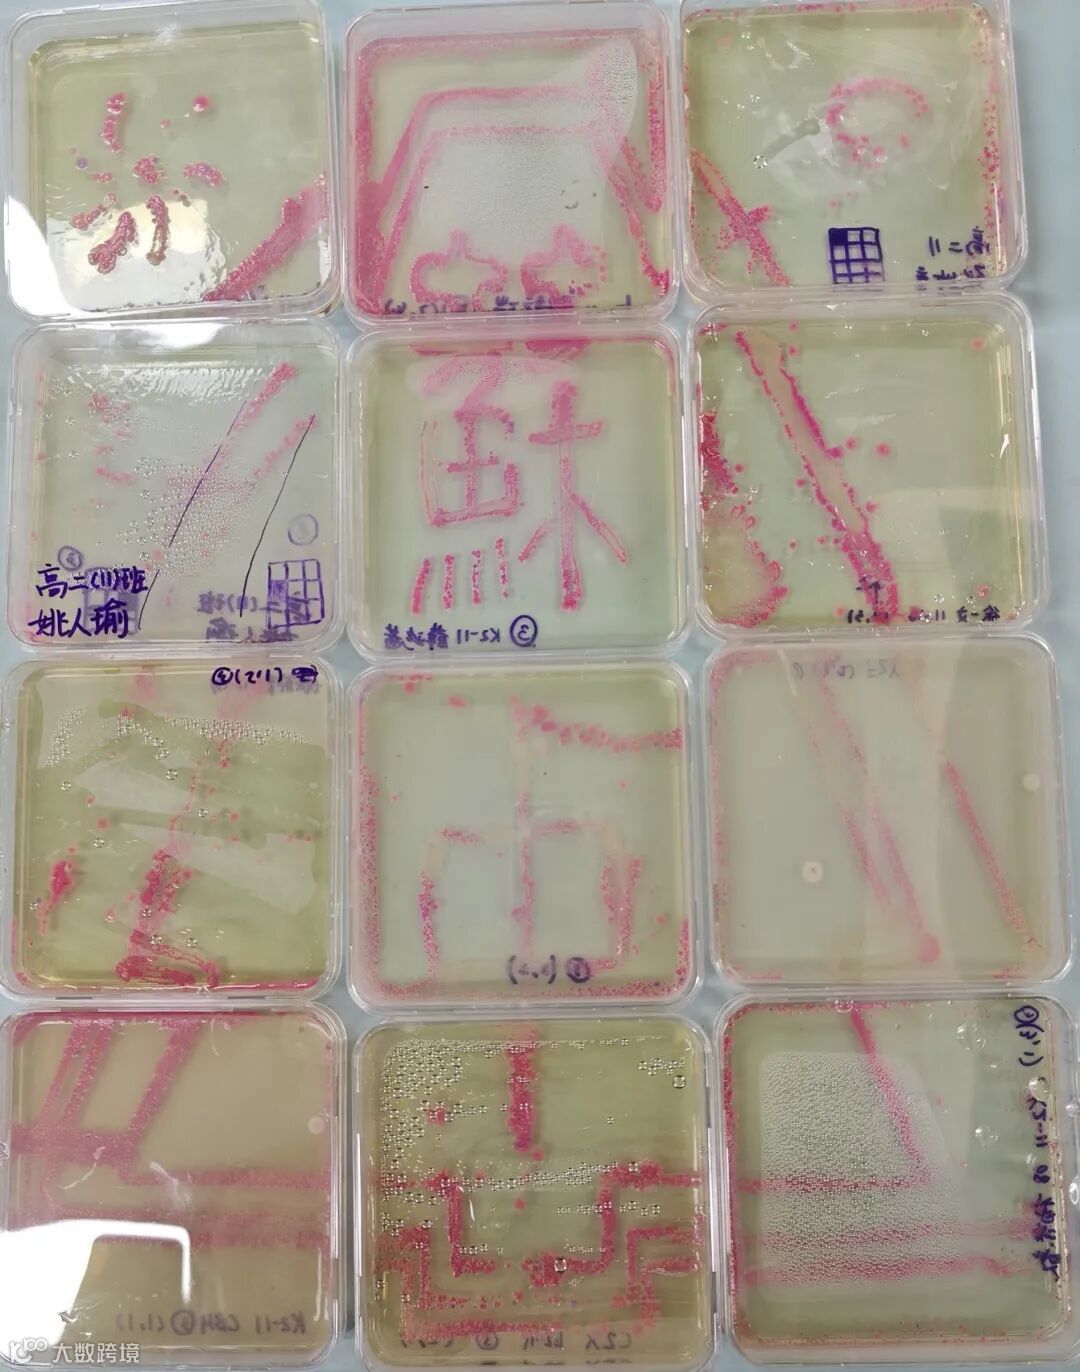

今天是2025年的最后一天
也是府学建校990周年收官之日
在这特别的日子里
我校学子用“会发光”的细菌作画
绘就一场科学与艺术交织的校庆献礼
这些探索与惊喜并存的瞬间
定格在苏州中学2025的最后一页
本期微信,与您分享
你以为的中学生物学实验,是显微镜下的细胞观察?是试管里的试剂反应?苏中学子告诉你:生物课还能玩出艺术新高度!这次实践活动,我们用转基因技术改造大肠杆菌,让它们带上绿色荧光(还有隐藏款彩色荧光),成为会发光的“生物颜料”!而LB琼脂培养基,就是承载创意的“特殊画布”,接种环化身画笔,37℃恒温培养箱里,细菌慢慢生长,荧光逐渐显现,一幅独一无二的“发光校庆画”就此诞生。这场近半年的实践活动,每一步都藏着热爱与坚持!
5 月,生物组教师赴园区冷泉港学习中心交流,带回实验质粒和目的菌种,研究性学习小组率先“试水”,细菌转化、分离、培养,在一次次失败与成功的尝试中解锁“荧光密码”。

 上图为生物组老师指导学生进行细菌转化实验中
上图为生物组老师指导学生进行细菌转化实验中
6月,“转基因技术的原理和应用”公开课中,石虹梅老师带领同学们研学转基因技术,同时布置“菌墨丹青・献礼苏中”的生物实验任务。

12月,孙群懿、顾梦琪等老师带领全体高二生物选修班,俞明月老师带领伟长初一班级,高三部分班级加盟,以班级为单位组队创作,用细菌当“颜料”,培养基作“画布”,合力创作“菌墨丹青表深情”的生物艺术画。理科生化身“生物艺术家”,“990”数字、苏中LOGO、范仲淹肖像、校园标志性建筑,都成了画布上的灵感,STEAM综合素养在创作中悄悄升级。
上图为三种颜色的菌液及用菌液作成的图
12月30日上午,生物组老师们按照同学的实验设计,按序排列培养皿,小心翼翼“开盲盒”。打开皿盖的瞬间,课本里的“转基因技术”“荧光蛋白”变成可触摸、可观赏的“生命展品”,每一幅定格细菌生长形成的图案,都凝聚着师生的集体智慧。


上图为高三13班作品,
左为设计图,右为由荧光细菌制成的图


上图为高三14班作品,
左为设计图,右为由荧光细菌制成的图
《高二各班作品,可向右滑动查看》
早在半年前,我们就已经在生物实验室中初步进行细菌的转化实验,将含绿色荧光蛋白基因的质粒导入大肠杆菌,在此之前,我从未想过自己的学习生活可以离“高大上”的基因工程如此之近,也未曾料到转基因大肠杆菌竟可以用于创意绘图,作为献给母校990年诞辰的一份礼物。
此次实验活动,处处都体现出了生物实验所需的严谨、认真等特质,不仅要求转化细菌时操作符合规范、分毫不差,也要求其它模块不掉链子、相辅相成。比如,根据细菌作画的特性绘制出线条简笔底稿后,我们班中的每位同学都需要“认领”一角绘图任务,与纸上作画又不同,接种大肠杆菌既考验同学们的美术功底,又对大家的实验操作、控制手上力度大小等等有着很高的要求,可以说没有大家的通力合作,就没有最终完整图画的呈现。以转基因细菌作画,不仅表现了拥抱现代科技的创意精神,更饱含着我们对于母校的一腔赤诚热爱之情,愿我苏中,乘着科技之风,永远飞翔在科学前沿。
——高三13班刘煦菲
在高三分秒必争的复习节奏中,突然有了自己设计图画,用培养皿作画,为母校献礼的机会,这次生物实验对我们班每个人都显得格外奢侈而珍贵。为了呈现最完美的方案,我们班同学利用晚自习,一遍遍地推翻重来。从粗糙的草图到精密的定稿,设计图的反复修改修改,培养皿上谨小慎微地作画,见证了我们精益求精的精神。虽然时间紧、任务重,但想到这是为府学990校庆献礼,这份努力便有了特殊的重量与意义。能以苏中学子的课堂所学,致敬这座千年府学,所有的投入都让我们感到无比值得。
——高三14班方昊东
六月份第一次做细菌转化实验,结果比较罕见,平板上仅有一个发荧光的菌落。在反思总结可能原因后,我课后进行了第二次实验,避免可能出现的问题后结果较好,培养基上菌落分布相对均匀。
经过转化实验与荧光菌涂布作画实验,我收获颇丰,首先,亲身经历课本上的实验后会发现并没有想象中的简单,典型的例子就是涂布和接种等操作,既要保证菌液已接种到培养基上又要尽量防止培养基的损坏;其次是实验操作的规范性,做之前脑子里想过一遍的流程很可能在中途被遗漏,这些都要靠实践去积累提升。并且实验过程中出现的很多现象平时在课本、题目中可能根本不会涉及,就如第一次实验的结果,这给了我机会去反思去复盘实验过程,提高了我对实验操作的熟练程度,同时也增强了对实验操作思考的完备程度。
——高三13班曹怿轩
这次的荧光菌实验让我们成功地将书本上的生物知识运用到实践中。从画稿的设计,划线法的尝试到最后全班合作完成一幅作品,每一步都是对我们创造能力、应用能力和团队合作能力的锻炼。虽然成品还有很多不足,但这幅独一无二的作品是全班同学努力的结晶,会永远留存在记忆当中。希望以后还能有更多这样的活动。
——高二13班周芷娴
平板划线是一次非常特别的体验!我们第一次踏进了无菌实验室,认识并使用了涂布器,接种环,通风橱…这次体验让我感触最大的就是认知和实践之间存在很大的差距:当我真正拿起接种环,蘸取菌液尝试在培养基上划线时,深浅崎岖的破损才让我意识到真正上手的艰难。心中描摹好图案,摆正接种环,稳住手,然后果断下笔。经过不断的练习,最终也划出了满意的图案。生物之魅力正是在于此,你最终看到培养基的那刻,才会发觉小小的荧光细菌竟能展现出如此炫彩的颜色,生长成美丽的图案。未来,生物仍有更多奥秘值得我们求真探索。
——高二12班曹语鑫
细菌虽小终成燎原气象,生物虽微终改寥廓人间。结构简单的细菌凝聚,最终展现宏大的图景;形态微小的生物演化,最终改变世界的面貌。
——高二14班 徐正钢
《颜氏家训》有言:讲论文章若春花绽,躬身力行似果实累。生物不仅在于苏中雪松之上的阳光,也凝结于培养皿闪烁的水珠中。生物是一门以实验为基础的学科,而这次的活动经历让我们切实感受到了生物学科的魅力,清晰地为我们展现了生命的精妙和和谐——我们在透明的世界中播种色彩,收获心中喷薄而出的奇迹。
——高二15班毛朱辰
正如木心所言:所谓深渊,下去,也是鹏程万里。大肠杆菌的划线工作就可谓是“一步差错,以致深渊”,但完成后的雪松让我认识到:每一步的汗水都会汇聚为未来的闪耀时刻。感谢这次活动,让我领略到永恒的生命回响,收获精神的富足。
——高二15班林逸程
许多人生物实验的刻板影响大多是庞杂枯燥的步骤与数据,然而荧光菌画图的活动却彰显出独属于理科实验的浪漫。在荧光菌划线过程中,我们不但对荧光蛋白相关的细菌基因工程有了更深刻的理解,也在以培养基为画板的实践中展现了创造力。这个活动让我受益匪浅。
——高二13班王梓瑜
用细菌绘画是一次很特别的体验。手中的画笔变成了细菌,画纸变成了培养基,本可以大手一挥完成的画作,现在需要小心再小心,谨慎再谨慎,一不小心就会划破培养基,造成瑕疵。本次细菌绘画让我们体会到了生物的奥妙,明白了做事要多些耐心和细心。希望之后还可以学习更多有趣的生物原理,通过生物这门学科发现世界的更多奥秘。
——高二12班王燕妮
本次培养基绘画实验,我们不仅学习了大肠杆菌的培养知识,进行了实践操作,更是在描摹范文正公画像的过程中重走了一遍圣贤的路径,并以这种融合现代科技与传统绘画的方式表达出对伟人与学校办学的历史的敬意,这一幅培养基拼图正是对苏中“大学境界”多元发展教育理念的生动诠释。
——高二10班马乙歌
从课本上的单调描述到培养基上生长着的菌落,从基本的操作要点到实验室中一丝不苟的严谨,这次实验不仅加深了我对知识点的理解,更让我明白了“纸上得来终觉浅“,实践才是检验真理的唯一标准。当所有人的作品拼成一幅完整的范仲淹画像,一股自豪感油然而生,在我心中播下了一颗真理的种子。
——高二10班陈司涵
今天,我们用荧光的轨迹
以生命为媒,以深情为笔
让科技有温度,让文化有载体
我们看到的不仅是荧光闪烁的画作
更是青年学子对生命科学的探索
这不止是一次生物实践
而是我们对母校最特别的告白
这不仅是跨学科融合的教学创新
更是对苏中学子“文理兼修、知行合一”的传承
再见,2025;再见,990周年!
你好,2026;你好,发光的我们!